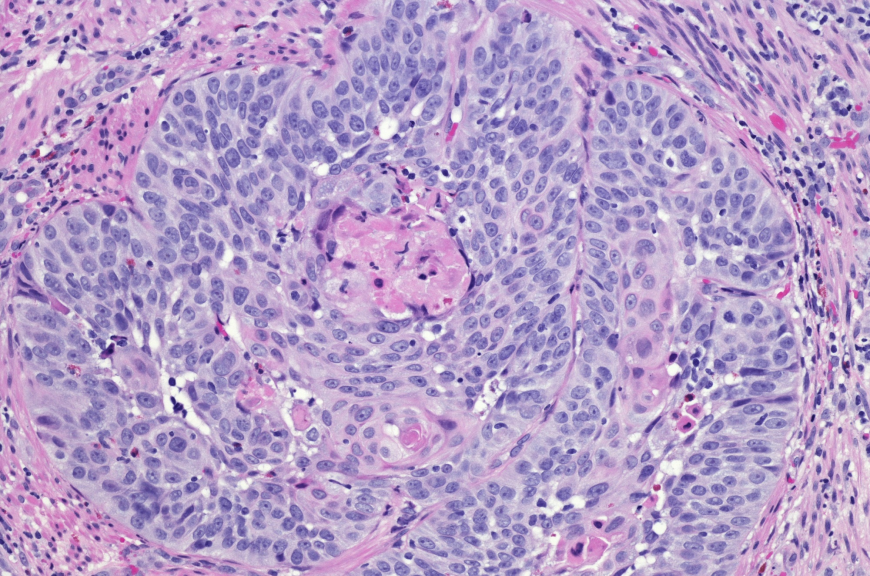
Advanced Non-Squamous and Squamous NSCLC Market: Size, Trends, and Growth Outlook

Advanced Non-Squamous and Squamous NSCLC Market: Size, Trends, and Growth Outlook
Market insights reveal that evolving market segments focusing on immunotherapies and targeted treatments contribute significantly to the expanding industry size.
The Advanced Non-Squamous and Squamous NSCLC market is witnessing robust expansion driven by innovative therapies and increasing global demand for effective lung cancer treatments. Ongoing advancements in targeted therapies and immunotherapies are shaping industry trends and opening new avenues for business growth. This makes the market dynamics highly promising for stakeholders.
Market Size and Overview
The advanced non-squamous and squamous NSCLC market is estimated to be valued at USD 11.67 Bn in 2025 and is expected to reach USD 18.99 Bn by 2032, growing at a compound annual growth rate (CAGR) of 7.2% from 2025 to 2032.
The Advanced Non-Squamous and Squamous NSCLC Market report highlights strong market revenue growth, driven by increasing prevalence of NSCLC, rising healthcare expenditure, and enhanced adoption of personalized medicine. Market insights reveal that evolving market segments focusing on immunotherapies and targeted treatments contribute significantly to the expanding industry size.
Investment Scenario
The investment climate in the Advanced Non-Squamous and Squamous NSCLC market remains healthy with increased venture capital influx and M&A activities. For instance, in early 2025, a top pharmaceutical company secured over USD 500 million funding to accelerate R&D in NSCLC therapies. Several market players are reallocating capital towards clinical trials and biotechnological innovations.
‣ Read More Related Articles : Exosome Therapeutics Emerging as Promising Area of Research
‣ Get more insights on : Advanced Non-Squamous and Squamous NSCLC Market
‣ Get this Report in Japanese Language: 進行性非扁平上皮癌および扁平上皮癌市場
‣ Get this Report in Korean Language: 고급비편평세포암및편평세포암NSCLC시장

 CoherentMI86
CoherentMI86